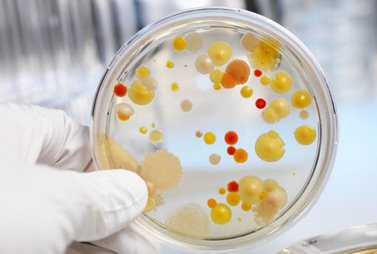
Анализ для выявления заболевания бактериальным вагинозом

Воспользуйтесь поиском по сайту:
Бактериальный вагиноз
Краткая характеристика заболевания
При бактериологическом исследовании в составе выделений обнаруживаются следующие бактерии: бактероиды, фузобактерии, клебсиелы и гарднерелла. Из-за наличия последней бактериальный вагиноз часто называют гарднереллезом.
Причины заболевания
Как уже было сказано выше, точные причины бактериального вагиноза – неизвестны. Врачи выделяют несколько факторов, которые предположительно провоцируют развитие болезни:
- гормональные – гормоны оказывают влияние на состояние микрофлоры влагалища. Известно, что бактериальный вагиноз редко встречается среди девушек-подростков, у которых уровень гормонов в крови ниже, чем у взрослых женщин;
- наличие внутриматочной спирали – риск появления инфекции возрастает в два раза;
- применение большого количества антибиотиков – препараты подавляют размножение лактобактерий и создают все условия для развития вредных микроорганизмов;
- сниженный иммунитет – лечение бактериального вагиноза может потребоваться после тяжелых болезней, поскольку они приводят к ослаблению защитных функций организма и способствуют размножению вредных бактерий.
В последние годы было доказано, что половым путем бактериальный вагиноз не передается, но некоторые венерические заболевания подавляют иммунитет и влияют на микрофлору влагалища, поэтому к выбору партнера все равно стоит подходить со всей возможной ответственностью.
Бактериальный вагиноз – симптомы и клиническая картина
В более чем 50% зарегистрированных случаев бактериальный вагиноз никак не проявляет себя. Неудивительно поэтому, что заболевание очень часто выявляется только на профилактическом осмотре у гинеколога. В оставшихся случаях размножение болезнетворных бактерий приводит к следующим последствиям:
- обильные выделения из влагалища, имеющие характерный неприятный запах рыбы. Их количество увеличивается после полового акта;
- слабый зуд в области половых органов;
- дискомфорт и жжение во время полового акта;
- боли при мочеиспускании (встречаются нечасто).
При отсутствии лечения бактериальный вагиноз приводит к серьезным последствиям. Бактериальный вагиноз у беременных провоцирует развитие осложнений при родах и преждевременное появление ребенка на свет, а также является одной из причин возникновения рака шейки матки. Кроме того, изменения состава микрофлоры влагалища влияют на общую сопротивляемость организма. Известно, что у больных женщин бактериальным вагинозом гораздо чаще фиксируются случаи заражения гонореей, хламидиозом, папилломавирусной инфекцией и другими крайне неприятными «болячками».
Для мужчин бактериальный вагиноз абсолютно безопасен. Он не передается половым путем, да и вообще считается чисто женской проблемой. Тем не менее, при диагнозе бактериальный вагиноз лечение должно начаться как можно быстрее, поскольку неприятный запах выделений и дискомфорт при половом акте не позволят паре жить нормальной, полноценной жизнью.
Бактериальный вагиноз у беременных
Бактериальный вагиноз при беременности проявляет себя после гормональной перестройки организма. Заболевание оказывает влияние на рост и развитие ребенка, может вызвать преждевременные роды и потому нуждается в своевременном лечении. Отсутствие неприятных симптомов не является основанием для отказа от врачебной помощи, так как речь в данном случае идет о жизни и здоровье малыша.
Как лечить бактериальный вагиноз?

- метронидазол, трихопол, метрогил, флагил – тормозят размножения бактерий, но могут вызвать побочные реакции (тошнота, рвота, расстройства пищеварения), поэтому препараты следует принимать под постоянным наблюдением врача;
- клиндамицин - выпускается в виде вагинальных свечей или крема. Вводится во влагалище один раз в день, перед сном;
- метрогил плюс – подавляет рост бактерий и предотвращает развитие молочницы. Препарат вводится во влагалище два раза в день – утром и вечером.
Если наблюдается бактериальный вагиноз при беременности, то перед приемом любого из вышеперечисленных препаратов необходимо проконсультироваться с врачом, который посоветует наиболее щадящее средство.
После устранения вредоносных бактерий необходимо позаботиться о восстановлении нормальной микрофлоры влагалища. Для этого прекрасно подойдут пробиотики – лекарства, содержащие живые полезные микроорганизмы. Наиболее популярные пробиотики – это линекс, бифидумбактерин, лактобактерин.
Видео с YouTube по теме статьи:
Информация является обобщенной и предоставляется в ознакомительных целях. При первых признаках болезни обратитесь к врачу. Самолечение опасно для здоровья!
В четырех дольках темного шоколада содержится порядка двухсот калорий. Так что если не хотите поправиться, лучше не есть больше двух долек в сутки.
























